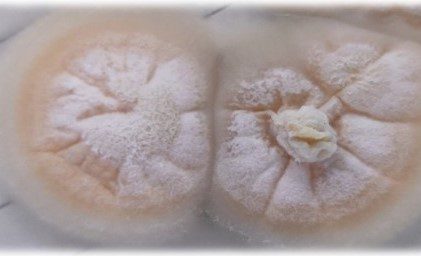

Personal investigador del Área de Enfermedades Infecciosas de Biodonostia que pertenecen al Servicio de Microbiología del Hospital Donostia, participa un año más en el Congreso Europeo de Microbiología Clínica y Enfermedades Infecciosas, ECCMID (Copenhague), en el que se han presentado abstract y trabajos de investigación, pero también y una serie de fotografías para la Art Gallery. Se trata de un espacio en el que se recogen fotografías relacionadas con la temática del Congreso, creando un TOP 5 para las consideradas más artísticas y publicándose todas ellas en el denominado Libro de Arte del Congreso.
A pesar de no haber logrado estar entre los cinco ganadores, tres de las fotos presentadas desde Biodonostia-OSI Donostialdea, han quedado entre las diez finalistas: Acremonium un hongo recuperado de las uñas de los dedos de pie o mano y aislado en el Hospital Universitario Donostia; qué ocurre cuando cerramos mal un bote de mermelada y aparecen hongos; y por último una placa de Nocardia cyriacigeorgica que se encuentra de las más frecuentes de nuestro entorno.
Desde que la pandemia asoló el mundo y se tuvieron que suspender los congresos de 2020 y 2021, y hacer online el de 2022, hay “otro congreso europeo” en paralelo donde los microbiólogos e infectólogos exhiben sus cualidades artísticas, escultura, pintura, prosa, fotografía, editándose posteriormente un libro. Además, las fotografías presentadas sirven de bienvenida a los congresistas ya que son ampliadas y colocadas en el salón de entrada al Congreso.
En 2023, desde Donostia, se han presentado trabajos en las categorías de fotografía y escritura, y como señalan los participantes “somos conscientes de la gran cantidad de trabajos que se han enviado, por lo que el hecho de que tres de nuestros trabajos estén entre los 10 finalistas es un honor para todo el Servicio.de Microbiología”.
ZORIONAK!!
A continuación las fotografías enviadas: